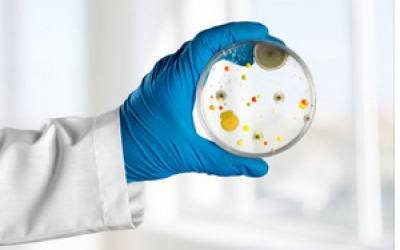

Banc de Recursos
18 Resultats trobats

¿Cómo contribuye la tutoría entre iguales al desarrollo de la comprensión lectora? Evidencias de diez años de práctica
DAVID DURAN GISBERTJESÚS RIBOSA MARTÍNEZ
MARTA FLORES COLL

20 principios fundamentales de la psicología para la enseñanza y el aprendizaje desde la educación infantil hasta la enseñanza secundaria
AMERICAN PSYCHOLOGICAL ASSOCIATIONJAVIER TOURÓN

Percepciones docentes sobre observación entre iguales: resistencias, agencia, procedimiento y objetivos de mejora
DAVID DURAN GISBERTESTER MIQUEL BERTRAN
JESÚS RIBOSA MARTÍNEZ
MARIONA CORCELLES SEUBA
MARTA FLORES COLL

Créer des classes de niveau : atouts ou freins à la réussite des élèves ?
AMAËL ANDRÉDAMIEN TESSIER
JONAS DIDISSE

Neuroeducación: Aportes al aprendizaje de la lectura en Educación Primaria
JOHN EDWAR GONZÁLEZ ARIAS
Espais d’aula confortables i orientats a promoure l’ús oral del català entre els alumnes que hi mostren dificultats
DAVID DURAN GISBERTJESÚS RIBOSA MARTÍNEZ
LAURA SÁNCHEZ
MARTA FLORES COLL

Los Objetivos de Desarrollo Sostenible, un reto para la escuela y el liderazgo escolar
CHARLES SLATERJON MARTÍNEZ RECIO
REYES HERNÁNDEZ CASTILLA